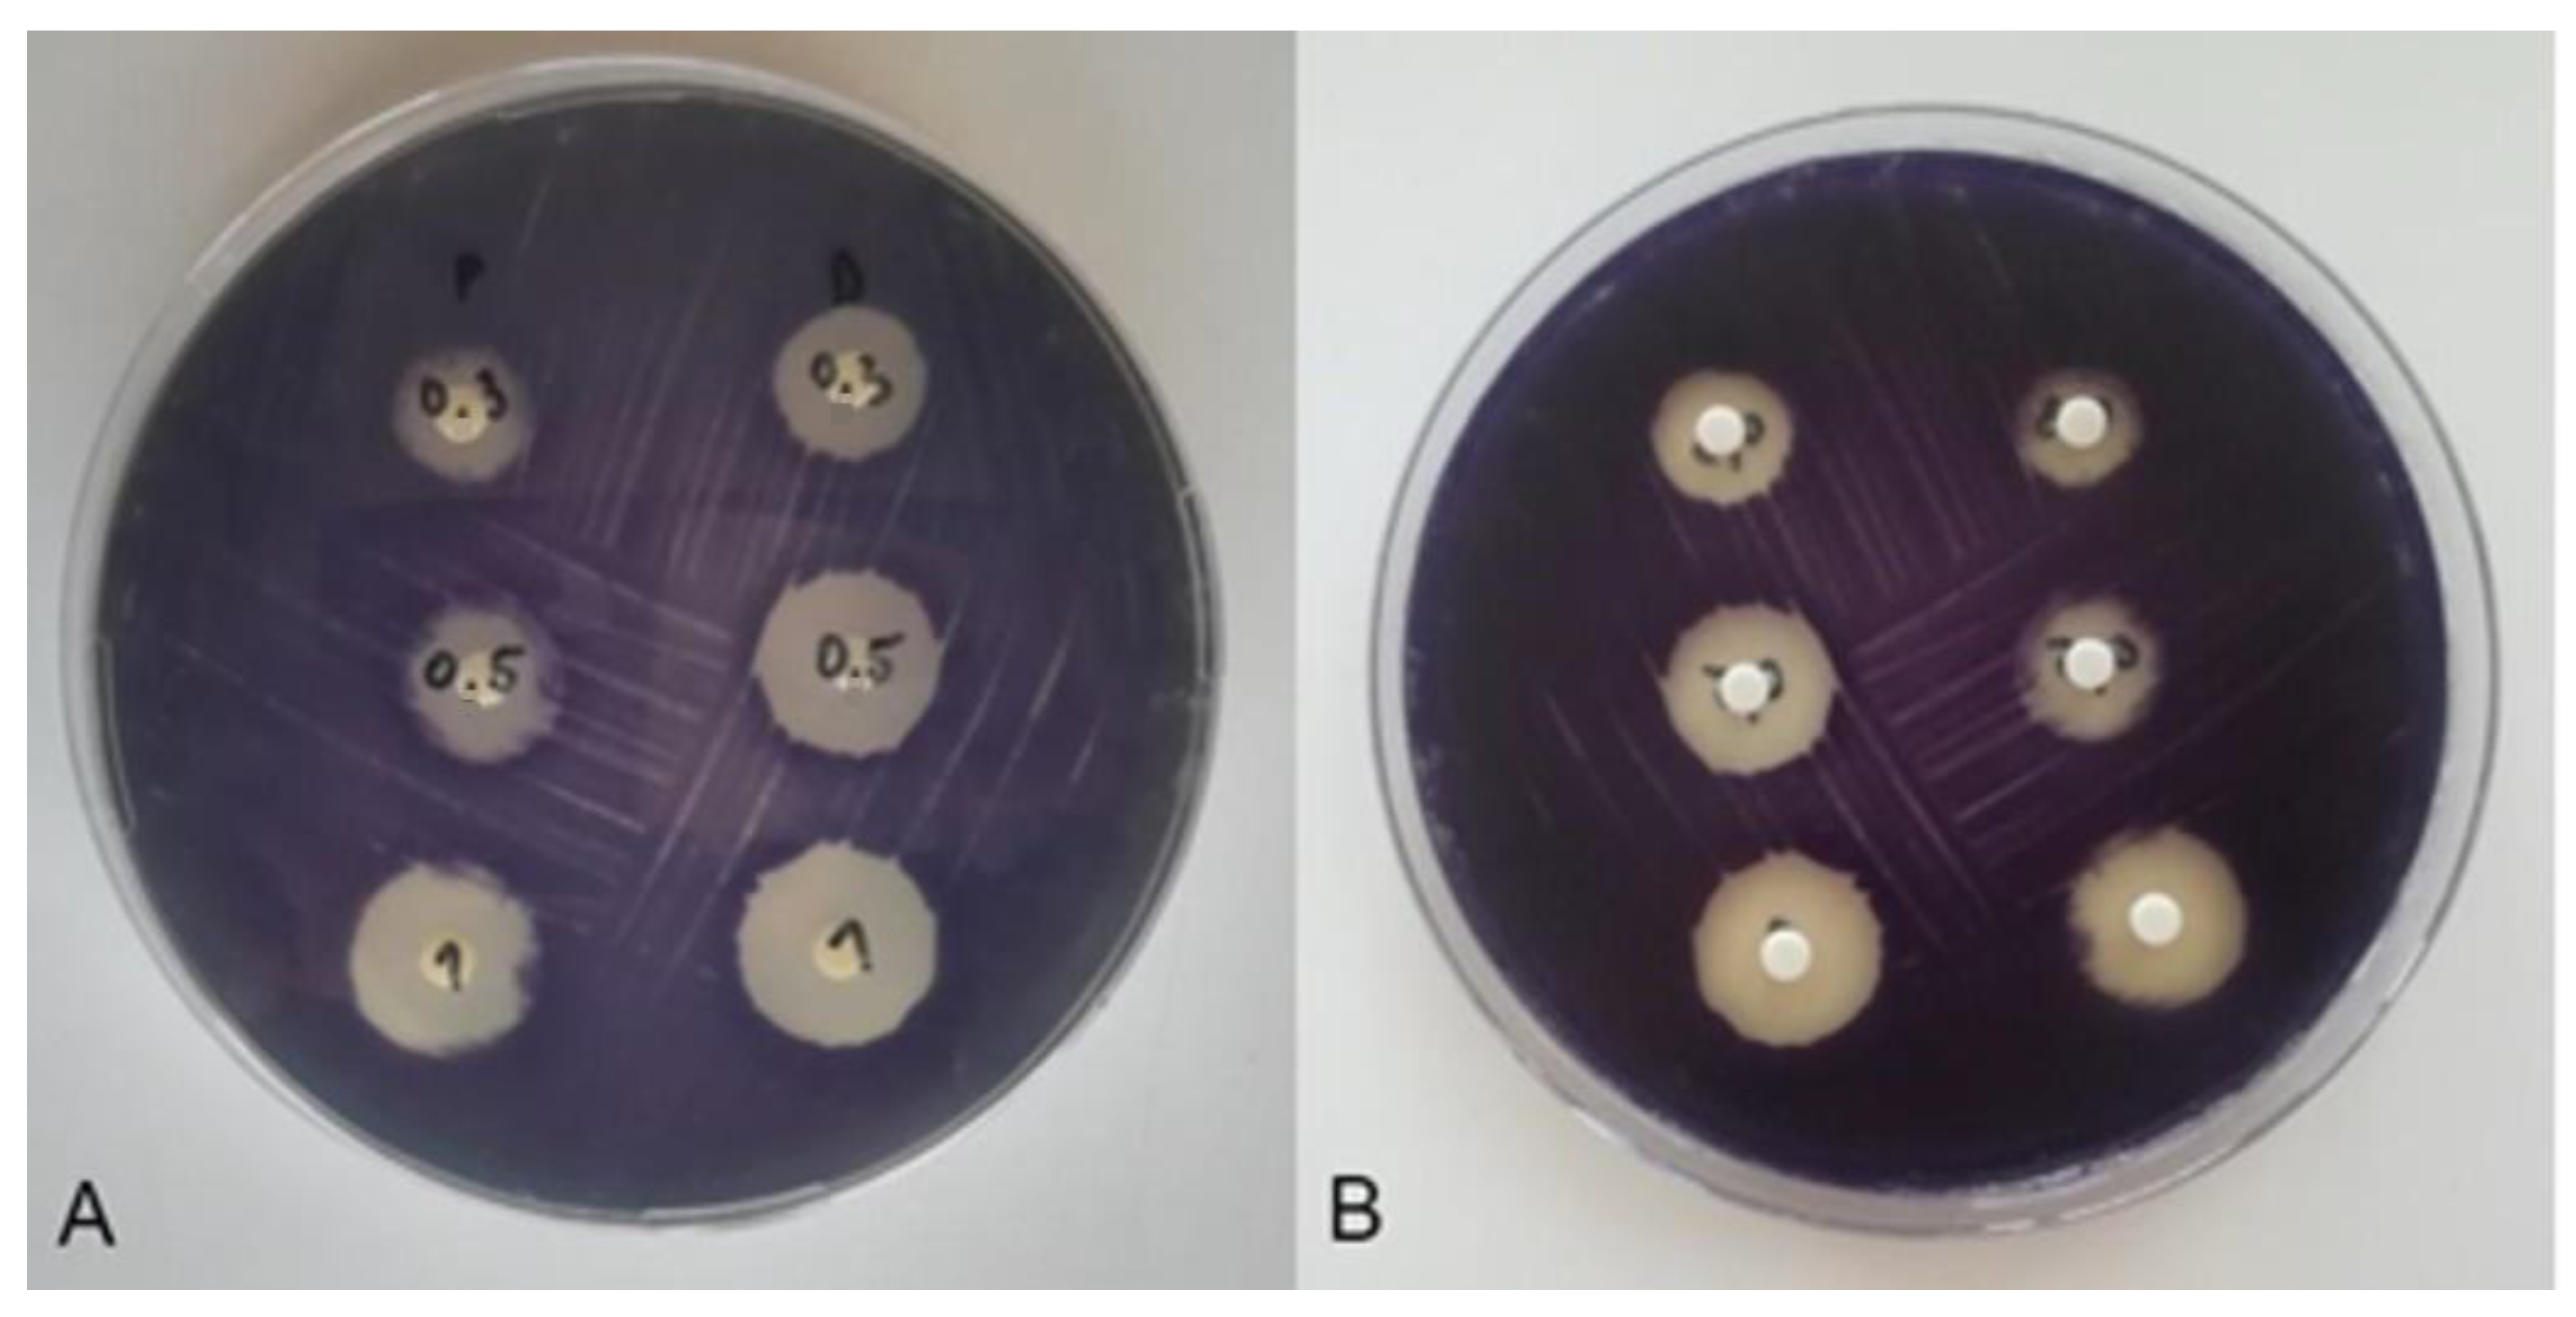

Comparison of the Efficiency of Selected Disinfectants against Planktonic and Biofilm Populations of Escherichia coli and Staphylococcus aureus
Abstract
1. Introduction
2. Materials and Methods
2.1. Bacterial Strain and Preparation of Inoculum
2.2. Disinfectants
2.3. Examination of Disinfectant Properties against Planktonic Forms
2.4. Biofilm Formation Assay
2.5. Examination of Disinfectants Properties against Microbial Cells in Biofilms
2.6. Anti-Quorum Sensing Activity
2.7. Statistical Analysis
3. Results
3.1. Influence of Disinfectants on Broth Cultures of Tested MOs
3.2. Biofilm Formation Ability
3.3. Influence of Disinfectants on Formed Biofilms on Steel Discs
3.4. Anti-Quorum Sensing Activity of Tested Disinfectants on Chromobacterium violaceum
4. Discussion
4.1. Influence of Disinfectants on Broth Cultures of Tested MOs
4.2. Biofilm Formation Ability
4.3. Influence of Disinfectants on Formed Biofilms
4.4. Anti-Quorum Sensing Activity
5. Conclusions
Author Contributions
Funding
Data Availability Statement
Conflicts of Interest
References
- Cabarkapa, I.; Levic, J.; Djuragic, O. Biofilm. Microbial pathogens and strategies for combating them. Sci. Tech. Ed. 2013, 1, 42–52. [Google Scholar]
- Stepanović, S.; Ćirković, I.; Ranin, L.; Svabić-Vlahović, M. Biofilm formation by Salmonella spp. and Listeria monocytogenes on plastic surface. Lett. Appl. Microbiol. 2004, 38, 428–432. [Google Scholar] [CrossRef] [PubMed]
- Møretrø, T.; Heir, E.; Nesse, L.L.; Vestby, L.K.; Langsrud, S. Control of Salmonella in food related environments by chemical disinfection. Food Res. Int. 2012, 45, 532–544. [Google Scholar] [CrossRef]
- Adetunji, V.O.; Isola, T.O. Crystal violet binding assay for assessment of biofilm formation by Listeria monocytogenes and Listeria spp. on wood, steel and glass surfaces. Glob. Vet. 2011, 6, 6–10. [Google Scholar]
- Chia, T.; Goulter, R.; McMeekin, T.; Dykes, G.; Fegan, N. Attachment of different Salmonella serovars to materials commonly used in a poultry processing plant. Food Microbiol. 2009, 26, 853–859. [Google Scholar] [CrossRef] [PubMed]
- de Jesus Pimentel-Filho, N.; de Freitas Martins, M.C.; Nogueira, G.B.; Mantovani, H.C.; Vanetti, M.C.D. Bovicin HC5 and nisin reduce Staphylococcus aureus adhesion to polystyrene and change the hydrophobicity profile and Gibbs free energy of adhesion. Int. J. Food Microbiol. 2014, 190, 1–8. [Google Scholar] [CrossRef] [PubMed]
- Di Ciccio, P.; Vergara, A.; Festino, A.; Paludi, D.; Zanardi, E.; Ghidini, S.; Ianieri, A. Biofilm formation by Staphylococcus aureus on food contact surfaces: Relationship with temperature and cell surface hydrophobicity. Food Control 2015, 50, 930–936. [Google Scholar] [CrossRef]
- Dula, S.; Ajayeoba, T.A.; Ijabadeniyi, O.A. Bacterial biofilm formation on stainless steel in the food processing environment and its health implications. Folia Microbiol. 2021, 66, 293–302. [Google Scholar] [CrossRef]
- Shi, X.; Zhu, X. Biofilm formation and food safety in food industries. Trends Food Sci. Technol. 2009, 20, 407–413. [Google Scholar] [CrossRef]
- Van Houdt, R.; Michiels, C. Biofilm formation and the food industry, a focus on the bacterial outer surface. J. Appl. Microbiol. 2010, 109, 1117–1131. [Google Scholar] [CrossRef]
- Møretrø, T.; Langsrud, S. Residential bacteria on surfaces in the food industry and their implications for food safety and quality. Compr. Rev. Food Sci. F. 2017, 16, 1022–1041. [Google Scholar] [CrossRef] [PubMed]
- Abebe, G.M. The role of bacterial biofilm in antibiotic resistance and food contamination. Int. J. Microbiol. 2020, 2020, 1705814. [Google Scholar] [CrossRef] [PubMed]
- Hall-Stoodley, L.; Costerton, J.W.; Stoodley, P. Bacterial biofilms: From the natural environment to infectious diseases. Nat. Rev. Microbiol. 2004, 2, 95–108. [Google Scholar] [CrossRef]
- Srey, S.; Jahid, I.K.; Ha, S.-D. Biofilm formation in food industries: A food safety concern. Food control 2013, 31, 572–585. [Google Scholar] [CrossRef]
- Yuan, L.; Sadiq, F.A.; Wang, N.; Yang, Z.; He, G. Recent advances in understanding the control of disinfectant-resistant biofilms by hurdle technology in the food industry. Crit. Rev. Food Sci. 2021, 61, 3876–3891. [Google Scholar] [CrossRef]
- Ziuzina, D.; Boehm, D.; Patil, S.; Cullen, P.; Bourke, P. Cold plasma inactivation of bacterial biofilms and reduction of quorum sensing regulated virulence factors. PLoS ONE 2015, 10, e0138209. [Google Scholar] [CrossRef]
- Condell, O.; Iversen, C.; Cooney, S.; Power, K.A.; Walsh, C.; Burgess, C.; Fanning, S. Efficacy of biocides used in the modern food industry to control Salmonella enterica and links between biocide tolerance and resistance to clinically relevant antimicrobial compounds. Appl. Environ. Microbiol. 2012, 78, 3087–3097. [Google Scholar] [CrossRef]
- Romeu, M.J.; Rodrigues, D.; Azeredo, J. Effect of sub-lethal chemical disinfection on the biofilm forming ability, resistance to antibiotics and expression of virulence genes of Salmonella Enteritidis biofilm-surviving cells. Biofouling 2020, 36, 101–112. [Google Scholar] [CrossRef]
- Jefferson, K.K. What drives bacteria to produce a biofilm? FEMS Microbiol. Lett. 2004, 236, 163–173. [Google Scholar] [CrossRef]
- Chmielewski, R.; Frank, J. Biofilm formation and control in food processing facilities. Compr. Rev. Food Sci. Food Saf. 2003, 2, 22–32. [Google Scholar] [CrossRef]
- ISO 16649-2:2001; Horizontal Method for the Enumeration of Beta-Glucuronidase-Positive Escherichia coli—Part 2: Colony-Count Technique at 44 °C Using 5-bromo-4-chloro-3-indolyl beta-D-glucuronide. Microbiology of the Food Chain. International Organization for Standardization: Geneva, Switzerland.
- McClean, K.H.; Winson, M.K.; Fish, L.; Taylor, A.; Chhabra, S.R.; Camara, M.; Daykin, M.; Lamb, J.H.; Swift, S.; Williams, P. Quorum sensing and Chromobacterium violaceum: Exploitation of violacein production and inhibition for the detection of N-acylhomoserine lactones. Microbiology 1997, 143, 3703–3711. [Google Scholar] [CrossRef] [PubMed]
- Kampf, G.; Meyer, B.; Goroncy-Bermes, P. Comparison of two test methods for the determination of sufficient antimicrobial activity of three commonly used alcohol-based hand rubs for hygienic hand disinfection. J. Hosp. Infect. 2003, 55, 220–225. [Google Scholar] [CrossRef] [PubMed]
- Čabarkapa, I.; Čolović, R.; Đuragić, O.; Popović, S.; Kokić, B.; Milanov, D.; Pezo, L. Anti-biofilm activities of essential oils rich in carvacrol and thymol against Salmonella Enteritidis. Biofouling 2019, 35, 361–375. [Google Scholar] [CrossRef]
- Tomičić, R.; Čabarkapa, I.; Vukmirović, Đ.; Lević, J.; Tomičić, Z. Influence of growth conditions on biofilm formation of Listeria monocytogenes. Food Feed Res. 2016, 43, 19–24. [Google Scholar] [CrossRef]
- Stepanović, S.; Ćirković, I.; Mijač, V.; Švabić-Vlahović, M. Influence of the incubation temperature, atmosphere and dynamic conditions on biofilm formation by Salmonella spp. Food Microbiol. 2003, 20, 339–343. [Google Scholar] [CrossRef]
- Venkadesaperumal, G.; Rucha, S.; Sundar, K.; Shetty, P.H. Anti-quorum sensing activity of spice oil nanoemulsions against food borne pathogens. LWT-Food Sci. Tech. 2016, 66, 225–231. [Google Scholar] [CrossRef]
- Cabeça, T.K.; Pizzolitto, A.C.; Pizzolitto, E.L. Activity of disinfectants against foodborne pathogens in suspension and adhered to stainless steel surfaces. Braz. J. Microbiol. 2012, 43, 1112–1119. [Google Scholar] [CrossRef]
- Surdeau, N.; Laurent-Maquin, D.; Bouthors, S.; Gellé, M.-P. Sensitivity of bacterial biofilms and planktonic cells to a new antimicrobial agent, Oxsil® 320N. J. Hosp. Infect. 2006, 62, 487–493. [Google Scholar] [CrossRef]
- Speers, J.; Gilmour, A. The influence of milk and milk components on the attachment of bacteria to farm dairy equipment surfaces. J. Appl. Bacteriol. 1985, 59, 325–332. [Google Scholar] [CrossRef]
- Notermans, S.; Dormans, J.; Mead, G. Contribution of surface attachment to the establishment of microorganisms in food processing plants: A review. Biofouling 1991, 5, 21–36. [Google Scholar] [CrossRef]
- Rossoni, E.; Gaylarde, C. Comparison of sodium hypochlorite and peracetic acid as sanitising agents for stainless steel food processing surfaces using epifluorescence microscopy. Int. J. Food Microbiol. 2000, 61, 81–85. [Google Scholar] [CrossRef] [PubMed]
- Tomičić, R.; Tomičić, Z.; Thaler, N.; Humar, M.; Raspor, P. Factors influencing adhesion of bacteria Escherichia coli, Pseudomonas aeruginosa, Staphylococcus aureus and yeast Pichia membranifaciens to wooden surfaces. Wood Sci. Tech. 2020, 54, 1663–1676. [Google Scholar] [CrossRef]
- Verraes, C.; Van Boxstael, S.; Van Meervenne, E.; Van Coillie, E.; Butaye, P.; Catry, B.; de Schaetzen, M.A.; Van Huffel, X.; Imberechts, H.; Dierick, K. Antimicrobial resistance in the food chain: A review. Int. J. Environ. Res. Public Health 2013, 10, 2643–2669. [Google Scholar] [CrossRef] [PubMed]
- Morente, E.O.; Fernández-Fuentes, M.A.; Burgos, M.J.G.; Abriouel, H.; Pulido, R.P.; Gálvez, A. Biocide tolerance in bacteria. Int. J. Food Microbiol. 2013, 162, 13–25. [Google Scholar] [CrossRef] [PubMed]
- Hegstad, K.; Langsrud, S.; Lunestad, B.T.; Scheie, A.A.; Sunde, M.; Yazdankhah, S.P. Does the wide use of quaternary ammonium compounds enhance the selection and spread of antimicrobial resistance and thus threaten our health? Microb. Drug Res. 2010, 16, 91–104. [Google Scholar] [CrossRef]
- Costa, S.A.d.S.; Paula, O.F.P.d.; Silva, C.R.G.; Leão, M.V.P.; Santos, S.S.F.D. Stability of antimicrobial activity of peracetic acid solutions used in the final disinfection process. Braz. Oral Res. 2015, 29, 1–6. [Google Scholar] [CrossRef]
- Holah, J.; Higgs, C.; Robinson, S.; Worthington, D.; Spenceley, H. A conductance-based surface disinfection test for food hygiene. Lett. Appl. Microbiol. 1990, 11, 255–259. [Google Scholar] [CrossRef]
- Meyer, B.; Cookson, B. Does microbial resistance or adaptation to biocides create a hazard in infection prevention and control? J. Hosp. Infect. 2010, 76, 200–205. [Google Scholar] [CrossRef]
- Marques, S.C.; Rezende, J.d.G.O.S.; Alves, L.A.d.F.; Silva, B.C.; Alves, E.; Abreu, L.R.d.; Piccoli, R.H. Formation of biofilms by Staphylococcus aureus on stainless steel and glass surfaces and its resistance to some selected chemical sanitizers. Braz. J. Microbiol. 2007, 38, 538–543. [Google Scholar] [CrossRef]
- Cos, P.; Tote, K.; Horemans, T.; Maes, L. Biofilms: An extra hurdle for effective antimicrobial therapy. Curr. Pharm. Des. 2010, 16, 2279–2295. [Google Scholar] [CrossRef]
- Hendry, E.; Worthington, T.; Conway, B.R.; Lambert, P. Antimicrobial efficacy of eucalyptus oil and 1, 8-cineole alone and in combination with chlorhexidine digluconate against microorganisms grown in planktonic and biofilm cultures. J. Antimicrob. Chemoth. 2009, 64, 1219–1225. [Google Scholar] [CrossRef] [PubMed]
- Leung, C.; Chan, Y.; Samaranayake, L.; Seneviratne, C. Biocide resistance of Candida and Escherichia coli biofilms is associated with higher antioxidative capacities. J. Hosp. Infect. 2012, 81, 79–86. [Google Scholar] [CrossRef] [PubMed]
- Smith, K.; Hunter, I.S. Efficacy of common hospital biocides with biofilms of multi-drug resistant clinical isolates. J. Med. Microbiol. 2008, 57, 966–973. [Google Scholar] [CrossRef]
- Vázquez-Sánchez, D.; Cabo, M.L.; Ibusquiza, P.S.; Rodríguez-Herrera, J.J. Biofilm-forming ability and resistance to industrial disinfectants of Staphylococcus aureus isolated from fishery products. Food control 2014, 39, 8–16. [Google Scholar] [CrossRef]
- Čabarkapa, I.; Škrinjar, M.; Lević, J.; Kokić, B.; Blagojev, N.; Milanov, D.; Suvajdžić, L. Biofilm forming ability of Salmonella Enteritidis in vitro. Acta Vet. Belgrade 2015, 65, 371–389. [Google Scholar]
- Solano, C.; García, B.; Valle, J.; Berasain, C.; Ghigo, J.M.; Gamazo, C.; Lasa, I. Genetic analysis of Salmonella Enteritidis biofilm formation: Critical role of cellulose. Mol. Microbiol. 2002, 43, 793–808. [Google Scholar] [CrossRef] [PubMed]
- White, A.; Gibson, D.; Kim, W.; Kay, W.; Surette, M. Thin aggregative fimbriae and cellulose enhance long-term survival and persistence of Salmonella. J. Bacteriol. 2006, 188, 3219–3227. [Google Scholar] [CrossRef] [PubMed]
- Poole, K. Mechanisms of bacterial biocide and antibiotic resistance. J. Appl. Microbiol. 2002, 92, 55S–64S. [Google Scholar] [CrossRef]
- Sundheim, G.; Langsrud, S.; Heir, E.; Holck, A. Bacterial resistance to disinfectants containing quaternary ammonium compounds. Int. Biodeterior. Biodegrad. 1998, 41, 235–239. [Google Scholar] [CrossRef]
- Adams, J.L.; McLean, R.J. Impact of rpoS deletion on Escherichia coli biofilms. Appl. Environ. Microbiol. 1999, 65, 4285–4287. [Google Scholar] [CrossRef]
- Bridier, A.; Briandet, R.; Thomas, V.; Dubois-Brissonnet, F. Resistance of bacterial biofilms to disinfectants: A review. Biofouling 2011, 27, 1017–1032. [Google Scholar] [CrossRef]
- Bridier, A.; Sanchez-Vizuete, P.; Guilbaud, M.; Piard, J.-C.; Naitali, M.; Briandet, R. Biofilm-associated persistence of food-borne pathogens. Food Microbiol. 2015, 45, 167–178. [Google Scholar] [CrossRef]
- Cloete, T.E. Resistance mechanisms of bacteria to antimicrobial compounds. Int. Biodeterior. Biodegrad. 2003, 51, 277–282. [Google Scholar] [CrossRef]
- Mah, T.-F.C.; O’Toole, G.A. Mechanisms of biofilm resistance to antimicrobial agents. Trends Microbiol. 2001, 9, 34–39. [Google Scholar] [CrossRef] [PubMed]
- Snoussi, M.; Noumi, E.; Punchappady-Devasya, R.; Trabelsi, N.; Kanekar, S.; Nazzaro, F.; Fratianni, F.; Flamini, G.; De Feo, V.; Al-Sieni, A. Antioxidant properties and anti-quorum sensing potential of Carumcopticum essential oil and phenolics against Chromobacterium violaceum. J. Food Sci. Technol. 2018, 55, 2824–2832. [Google Scholar] [CrossRef] [PubMed]
- Asghar, A.; Butt, M.S.; Shahid, M.; Huang, Q. Evaluating the antimicrobial potential of green cardamom essential oil focusing on quorum sensing inhibition of Chromobacterium violaceum. J. Food Sci. Technol. 2017, 54, 2306–2315. [Google Scholar]

| Absorbance (A) | Biofilm Production |
|---|---|
| A ≤ Ac | there is no biofilm production |
| Ac ≤ OD ≤ (2 × Ac) | weak biofilm production |
| (2 × Ac) < A ≤ (4 × Ac) | moderate biofilm production |
| (4 × Ac) < A | strong biofilm production |
| Tested MO | The Initial Number of MOs (log CFU/cm2) | Ambient Temperature (°C) | Disinfectant Concentration (%) | GE5min | GE10min | GE20min |
|---|---|---|---|---|---|---|
| S. aureus | 7.19 | 23 | 0.1 | 0.15 | 0.65 | - |
| 7.19 | 23 | 0.3 | 0.32 | 1.24 | - | |
| 7.19 | 23 | 0.5 | 2.05 | 3.63 | 4.46 | |
| 7.77 | 23 | 1.0 | 3.34 | 4.26 | 5.69 | |
| 7.77 | 23 | 2.0 | 7.77 | 7.77 | 7.77 | |
| E. coli | 7.73 | 23 | 0.1 | 0.63 | 1.11 | - |
| 7.73 | 23 | 0.3 | 1.45 | 2.99 | - | |
| 7.73 | 23 | 0.5 | 3.50 | 4.75 | 5.55 | |
| 7.91 | 23 | 1.0 | 4.08 | 4.54 | 5.73 | |
| 7.91 | 23 | 2.0 | 7.91 | 7.91 | 7.91 |
| Tested MO | The Initial Number of MOs (log CFU/cm2) | Ambient Temperature (°C) | Disinfectant Concentration (%) | GE5min | GE10min | GE20min |
|---|---|---|---|---|---|---|
| S. aureus | 7.19 | 23 | 0.1 | 0.20 | 0.96 | - |
| 7.19 | 23 | 0.3 | 0.46 | 1.50 | - | |
| 7.19 | 23 | 0.5 | 2.20 | 4.03 | 4.81 | |
| 7.77 | 23 | 1.0 | 3.50 | 4.31 | 6.62 | |
| 7.77 | 23 | 2.0 | 7.77 | 7.77 | 7.77 | |
| E. coli | 7.73 | 23 | 0.1 | 0.75 | 1.64 | - |
| 7.73 | 23 | 0.3 | 1.97 | 3.58 | - | |
| 7.73 | 23 | 0.5 | 3.76 | 5.04 | 5.75 | |
| 7.91 | 23 | 1.0 | 4.22 | 4.79 | 5.95 | |
| 7.91 | 23 | 2.0 | 7.91 | 7.91 | 7.91 |
| Factor | df | P S. aureus | P E. coli | D S. aureus | D E. coli |
|---|---|---|---|---|---|
| INM | 1 | 2.916 | 1.583 | 3.422 | 1.135 |
| Conc | 1 | 1.468 | 0.674 | 1.741 | 0.405 |
| Conc2 | 1 | 3.397 ** | 2.464 | 3.809 ** | 1.895 |
| t | 1 | 2.346 | 0.500 | 3.961 ** | 0.349 |
| t2 | 1 | 0.797 | 1.308 | 0.972 | 2.074 |
| INM × Conc | 1 | 3.784 ** | 2.995 | 4.298 ** | 2.385 |
| INM × t | 1 | 0.653 | 0.444 | 1.677 | 0.630 |
| Conc × t | 1 | 0.387 | 0.077 | 0.945 | 0.078 |
| Error | 6 | 3.926 | 6.476 | 5.707 | 7.999 |
| R2 | 0.968 | 0.942 | 0.954 | 0.925 | |
| adj R2 | 0.925 | 0.863 | 0.892 | 0.825 |
Disclaimer/Publisher’s Note: The statements, opinions and data contained in all publications are solely those of the individual author(s) and contributor(s) and not of MDPI and/or the editor(s). MDPI and/or the editor(s) disclaim responsibility for any injury to people or property resulting from any ideas, methods, instructions or products referred to in the content. |
© 2023 by the authors. Licensee MDPI, Basel, Switzerland. This article is an open access article distributed under the terms and conditions of the Creative Commons Attribution (CC BY) license (https://creativecommons.org/licenses/by/4.0/).
Share and Cite
Todorić, O.; Pezo, L.; Šarić, L.; Kolarov, V.; Varga, A.; Čabarkapa, I.; Kocić-Tanackov, S. Comparison of the Efficiency of Selected Disinfectants against Planktonic and Biofilm Populations of Escherichia coli and Staphylococcus aureus. Microorganisms 2023, 11, 1593. https://doi.org/10.3390/microorganisms11061593
Todorić O, Pezo L, Šarić L, Kolarov V, Varga A, Čabarkapa I, Kocić-Tanackov S. Comparison of the Efficiency of Selected Disinfectants against Planktonic and Biofilm Populations of Escherichia coli and Staphylococcus aureus. Microorganisms. 2023; 11(6):1593. https://doi.org/10.3390/microorganisms11061593
Chicago/Turabian StyleTodorić, Olja, Lato Pezo, Ljubiša Šarić, Violeta Kolarov, Ana Varga, Ivana Čabarkapa, and Sunčica Kocić-Tanackov. 2023. "Comparison of the Efficiency of Selected Disinfectants against Planktonic and Biofilm Populations of Escherichia coli and Staphylococcus aureus" Microorganisms 11, no. 6: 1593. https://doi.org/10.3390/microorganisms11061593
APA StyleTodorić, O., Pezo, L., Šarić, L., Kolarov, V., Varga, A., Čabarkapa, I., & Kocić-Tanackov, S. (2023). Comparison of the Efficiency of Selected Disinfectants against Planktonic and Biofilm Populations of Escherichia coli and Staphylococcus aureus. Microorganisms, 11(6), 1593. https://doi.org/10.3390/microorganisms11061593

